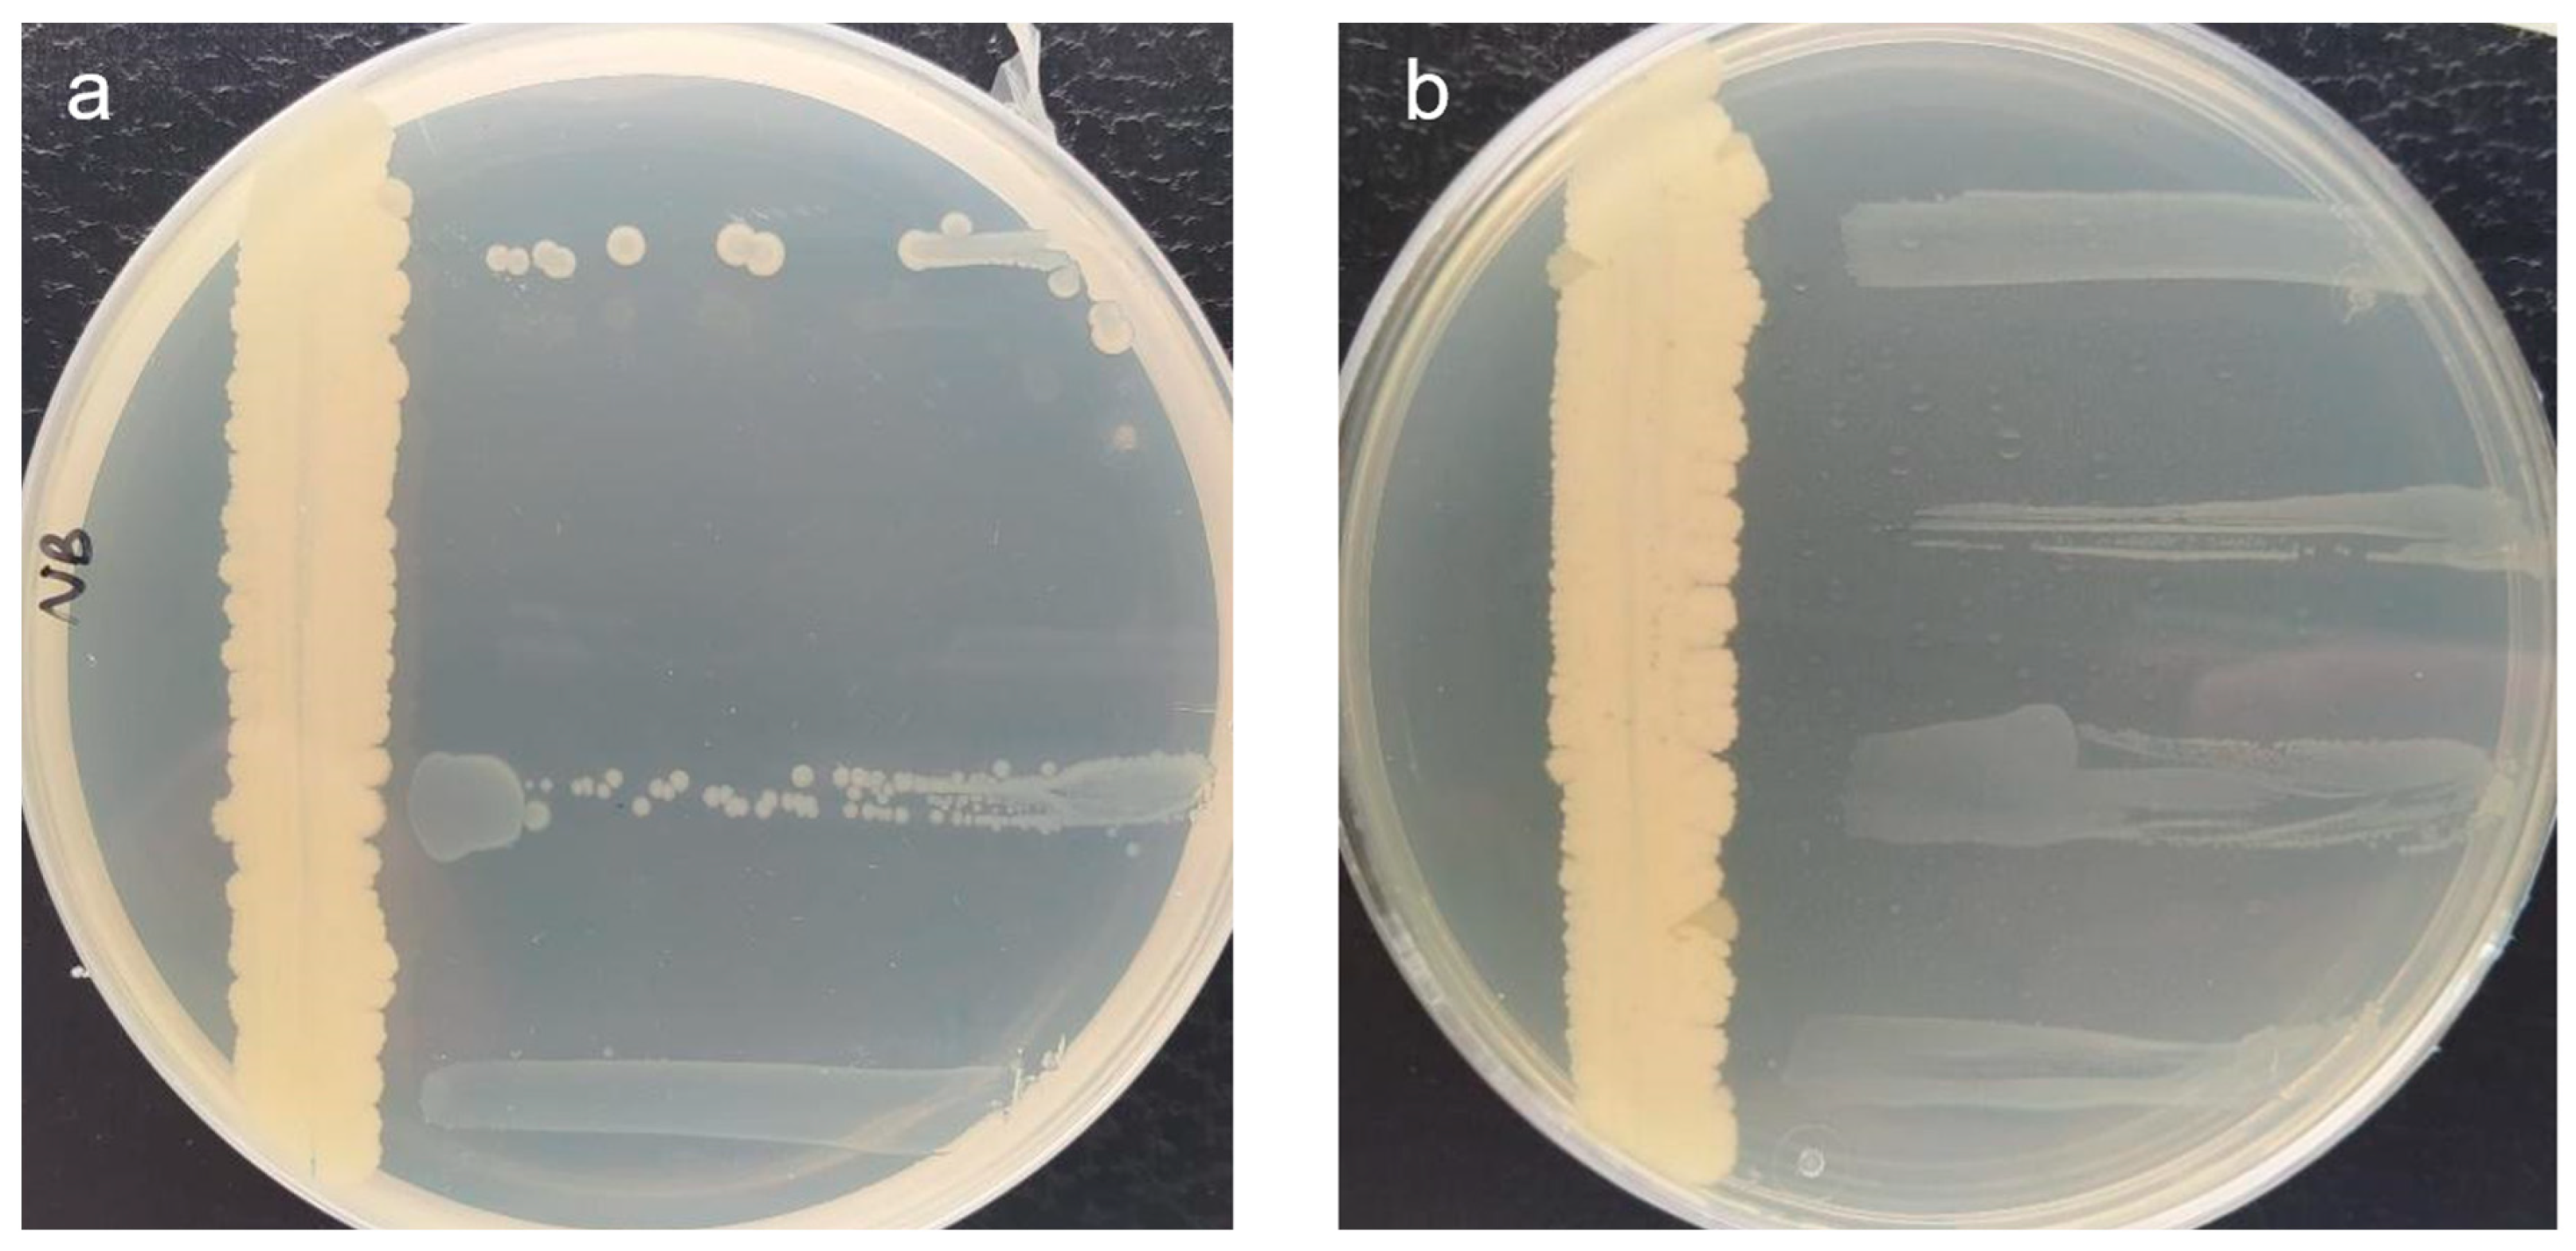
Microorganisms 11 01795 g001 Microorganisms 11 01795 g001

Screening for Novel Beneficial Environmental Bacteria for an Antagonism-Based Erwinia amylovora Biological Control
Abstract
1. Introduction
2. Materials and Methods
2.1. Bacterial Strains and Culture Conditions
2.2. In Vitro Antagonistic Activity: Cross-Streak and Double-Layer Agar Assays
2.3. Ex Vivo Antagonistic Activity: Assays on Detached Fruit
2.4. Characterization of Candidates with Antagonistic Activity
2.4.1. Exoenzymatic Activities
2.4.2. Nitrogen Fixation
2.5. Identification of Bacterial Strains by MALDI-TOF MS
2.6. Statistical Analysis
3. Results and Discussion
3.1. E. amylovora-Free Environments Can Be a Source of E. amylovora Antagonists
3.2. Ex Vivo Antagonistic Activity on Detached Fruit
3.2.1. Antagonistic Activity of the Candidate Strains against Fire Blight in Loquats
3.2.2. Antagonistic Activity of the Candidate Strains against Fire Blight in Pears
3.3. Characterization of Candidates with Antagonistic Activity
3.4. Identification of Bacterial Strains by MALDI-TOF MS
4. Conclusions
Author Contributions
Funding
Data Availability Statement
Acknowledgments
Conflicts of Interest
References
- Wallis, A.E.; Cox, K.D. Management of fire blight using pre-bloom application of prohexadione-calcium. Plant Dis. 2020, 104, 1048–1054. [Google Scholar] [CrossRef] [PubMed]
- Santander, R.D.; Català-Senent, J.F.; Figàs-Segura, À.; Biosca, E.G. From the roots to the stem: Unveiling pear root colonization and infection pathways by Erwinia amylovora. FEMS Microbiol. Ecol. 2020, 96, fiaa210. [Google Scholar] [CrossRef] [PubMed]
- Kim, Y.J.; Choi, D.H.; Choi, H.J.; Park, D.H. Risk of Erwinia amylovora transmission in viable but nonculturable (VBNC) state via contaminated pruning shears. Eur. J. Plant Pathol. 2023, 165, 433–445. [Google Scholar] [CrossRef]
- van der Zwet, T.; Orolaza-Halbrendt, N.; Zeller, W. Fire Blight: History, Biology, and Management; The American Phytopathological Society: St. Paul, MN, USA, 2016; ISBN 978-0-89054-483-9. [Google Scholar]
- Choi, H.J.; Kim, Y.J.; Lim, Y.J.; Park, D.H. Survival of Erwinia amylovora on surfaces of materials used in orchards. Res. Plant Dis. 2019, 25, 89–93. [Google Scholar] [CrossRef]
- Boucher, M.; Collins, R.; Harling, K.; Brind’Amour, G.; Hesler, S.; Wentworth, K.; Cox, K.; Loeb, G. Field evaluation of interactions between insects and Erwinia amylovora in a New York apple orchard. PhytoFrontiers 2021, 1, 94–103. [Google Scholar] [CrossRef]
- Zeng, Q.; Puławska, J.; Schachterle, J. Early events in fire blight infection and pathogenesis of Erwinia amylovora. J. Plant Pathol. 2021, 103, 13–24. [Google Scholar] [CrossRef]
- Bubán, T.; Orosz-Kovács, Z. The nectary as the primary site of infection by Erwinia amylovora (Burr.) Winslow et al.: A mini review. Plant Syst. Evol. 2003, 238, 183–194. [Google Scholar] [CrossRef]
- Thomson, S.V. Epidemiology of fire blight. In Fire Blight: The Disease and Its Causative Agent, Erwinia amylovora; Vanneste, J.L., Ed.; CABI Publishing: Wallingford Oxon, UK, 2000; pp. 9–36. ISBN 978-0-85199-294-5. [Google Scholar]
- Kharadi, R.R.; Schachterle, J.K.; Yuan, X.; Castiblanco, L.F.; Peng, J.; Slack, S.M.; Zeng, Q.; Sundin, G.W. Genetic dissection of the Erwinia amylovora disease cycle. Annu. Rev. Phytopathol. 2021, 59, 191–212. [Google Scholar] [CrossRef]
- Vanneste, J.L.; Eden-Green, S. Migration of Erwinia amylovora in host plant tissues. In Fire Blight: The Disease and Its Causative Agent, Erwinia amylovora; Vanneste, J.L., Ed.; CABI Publishing: Wallingford Oxon, UK, 2000; pp. 73–83. ISBN 978-0-85199-294-5. [Google Scholar]
- Slack, S.M.; Zeng, Q.; Outwater, C.A.; Sundin, G.W. Microbiological examination of Erwinia amylovora exopolysaccharide ooze. Phytopathology 2017, 107, 403–411. [Google Scholar] [CrossRef]
- Norelli, J.L.; Jones, A.L.; Aldwinckle, H.S. Fire blight management in the twenty-first century: Using new technologies that enhance host resistance in apple. Plant Dis. 2003, 87, 756–765. [Google Scholar] [CrossRef]
- Tancos, K.A.; Borejsza-Wysocka, E.; Kuehne, S.; Breth, D.; Cox, K.D. Fire blight symptomatic shoots and the presence of Erwinia amylovora in asymptomatic apple budwood. Plant Dis. 2017, 101, 186–191. [Google Scholar] [CrossRef]
- Hickey, K.D.; Orolaza-Halbrendt, N.; van der Zwet, T. The presence of endophytic Erwinia amylovora bacteria in symptomless apple tissue on orchard trees. Acta Hortic. 1999, 489, 453–458. [Google Scholar] [CrossRef]
- Santander, R.D.; Khodadadi, F.; Meredith, C.L.; Rađenović, Ž.; Clements, J.; Aćimović, S.G. Fire blight resistance, irrigation and conducive wet weather improve Erwinia amylovora winter survival in cankers. Front. Microbiol. 2022, 13, 1009364. [Google Scholar] [CrossRef]
- EPPO PM1/002(31) European and Mediterranean Plant Protection Organization EPPO A1 and A2 Lists of Pests Recommended for Regulation as Quarantine Pests. 2022. Available online: https://Gd.Eppo.Int/Taxon/ERWIAM/Documents (accessed on 25 May 2023).
- Anonymous. Commission Implementing Regulation (EU) 2019/2072 of 28 November 2019 establishing uniform conditions for the implementation of regulation (EU) 2016/2031 of the European Parliament and the Council, as regards protective measures against pests of plants, and repealing Commission Regulation (EC) No 690/2008 and amending Commission Implementing Regulation (EU) 2018/2019. OJEU 2019, L319, 1–279. [Google Scholar]
- Aćimović, S.G.; Santander, R.D.; Meredith, C.L.; Pavlović, Ž.M. Fire blight rootstock infections causing apple tree death: A case study in high-density apple orchards with Erwinia amylovora strain characterization. Front. Hortic. 2023, 2, 1082204. [Google Scholar] [CrossRef]
- Gaganidze, D.L.; Aznarashvili, M.A.; Sadunishvili, T.A.; Abashidze, E.O.; Gureilidze, M.A.; Gvritishvili, E.S. Fire blight in Georgia. Ann. Agrar. Sci. 2018, 16, 12–16. [Google Scholar] [CrossRef]
- Sánchez-Hernández, E.; Buzón-Durán, L.; Lorenzo-Vidal, B.; Martín-Gil, J.; Martín-Ramos, P. Physicochemical characterization and antimicrobial activity against Erwinia amylovora, Erwinia vitivora, and Diplodia seriata of a light purple Hibiscus syriacus L. cultivar. Plants 2021, 10, 1876. [Google Scholar] [CrossRef] [PubMed]
- Förster, H.; McGhee, G.C.; Sundin, G.W.; Adaskaveg, J.E. Characterization of streptomycin resistance in isolates of Erwinia amylovora in California. Phytopathology 2015, 105, 1302–1310. [Google Scholar] [CrossRef]
- Aćimović, S.G.; Zeng, Q.; McGhee, G.C.; Sundin, G.W.; Wise, J.C. Control of fire blight (Erwinia amylovora) on apple trees with trunk-injected plant resistance inducers and antibiotics and assessment of induction of pathogenesis-related protein genes. Front. Plant Sci. 2015, 6, 16. [Google Scholar] [CrossRef]
- Dagher, F.; Olishevska, S.; Philion, V.; Zheng, J.; Déziel, E. Development of a novel biological control agent targeting the phytopathogen Erwinia amylovora. Heliyon 2020, 6, e05222. [Google Scholar] [CrossRef]
- Sundin, G.W.; Wang, N. Antibiotic resistance in plant-pathogenic bacteria. Annu. Rev. Phytopathol. 2018, 56, 161–180. [Google Scholar] [CrossRef] [PubMed]
- Knecht, L.E.; Heinrich, N.; Born, Y.; Felder, K.; Pelludat, C.; Loessner, M.J.; Fieseler, L. Bacteriophage S6 requires bacterial cellulose for Erwinia amylovora infection. Environ. Microbiol. 2022, 24, 3436–3450. [Google Scholar] [CrossRef] [PubMed]
- Doukkali, L.; Radouane, N.; Ezrari, S.; Tahiri, A.; Tazi, B.; Guenoun, F.; Amiri, S.; Lahlali, R. Lessons learnt from the fire blight epidemics: A mini review. Indian Phytopathol. 2022, 75, 611–625. [Google Scholar] [CrossRef]
- Cabrefiga, J.; Bonaterra, A.; Montesinos, E. Mechanisms of antagonism of Pseudomonas fluorescens EPS62e against Erwinia amylovora, the causal agent of fire blight. Int. Microbiol. 2007, 10, 123–132. [Google Scholar]
- Sánchez-Hernández, E.; Buzón-Durán, L.; Cuchí-Oterino, J.A.; Martín-Gil, J.; Lorenzo-Vidal, B.; Martín-Ramos, P. Dwarf pomegranate (Punica granatum L. var. Nana): Source of 5-HMF and bioactive compounds with applications in the protection of woody crops. Plants 2022, 11, 550. [Google Scholar] [CrossRef]
- Fontana, R.; Macchi, G.; Caproni, A.; Sicurella, M.; Buratto, M.; Salvatori, F.; Pappadà, M.; Manfredini, S.; Baldisserotto, A.; Marconi, P. Control of Erwinia amylovora growth by Moringa oleifera leaf extracts: In vitro and in planta effects. Plants 2022, 11, 957. [Google Scholar] [CrossRef]
- Martinko, K.; Ivanković, S.; Đermić, E.; Đermić, D. Phenylboronic acid as a novel agent for controlling plant pathogenic bacteria. Pest Manag. Sci. 2022, 78, 2417–2422. [Google Scholar] [CrossRef]
- Zeng, Q.; Johnson, K.; Mukhtar, S.; Nason, S.; Huntley, R.; Millet, F.; Yang, C.-H.; Hassani, M.A.; Zuverza-Mena, N.; Sundin, G.W. Aureobasidium pullulans from the fire blight biocontrol product, blossom protect, induces host resistance in apple flowers. Phytopathology 2023. [Google Scholar] [CrossRef]
- Smits, T.H.M.; Rezzonico, F.; Kamber, T.; Blom, J.; Goesmann, A.; Frey, J.E.; Duffy, B. Complete genome sequence of the fire blight pathogen Erwinia amylovora CFBP 1430 and comparison to other Erwinia spp. MPMI 2010, 23, 384–393. [Google Scholar] [CrossRef]
- Wilson, M. Interactions between the biological control agent Pseudomonas fluorescens A506 and Erwinia amylovora in pear blossoms. Phytopathology 1993, 83, 117. [Google Scholar] [CrossRef]
- Aldwinckle, H.S.; Bhaskara Reddy, M.V.; Norelli, J.L. Evaluation of control of fire blight infection of apple blossoms and shoots with SAR inducers, biological agents, a growth regulator copper compounds, and other materials. Acta Hortic. 2002, 590, 325–331. [Google Scholar] [CrossRef]
- Ishimaru, C. New medium for detecting Erwinia amylovora and its use in epidemiological studies. Phytopathology 1984, 74, 1342. [Google Scholar] [CrossRef]
- Paulin, J.P.; Samson, R. Le feu bactérien en France. II. Caractères des souches d’ Erwinia amylovora (Burril) Winslow et al. 1920, isolées du foyer franco-belge. Ann. Phytopathol. 1973, 5, 389–397. [Google Scholar]
- Donat, V.; Biosca, E.G.; Peñalver, J.; López, M. Exploring diversity among Spanish strains of Erwinia amylovora and possible infection sources. J. Appl. Microbiol. 2007, 103, 1639–1649. [Google Scholar] [CrossRef]
- Donat, V.; Biosca, E.G.; Rico, A.; Penalver, J.; Borruel, M.; Berra, D.; Basterretxea, T.; Murillo, J.; López, M.M. Erwinia amylovora strains from outbreaks of fire blight in Spain: Phenotypic characteristics. Ann. Appl. Biol. 2005, 146, 105–114. [Google Scholar] [CrossRef]
- Lemos, M.L.; Toranzo, A.E.; Barja, J.L. Antibiotic activity of epiphytic bacteria isolated from intertidal seaweeds. Microb. Ecol. 1985, 11, 149–163. [Google Scholar] [CrossRef]
- Iacobellis, N.S.; Lo Cantore, P.; Capasso, F.; Senatore, F. Antibacterial activity of Cuminum cyminum L. and Carum carvi L. essential oils. J. Agric. Food Chem. 2005, 53, 57–61. [Google Scholar] [CrossRef]
- Santander, R.D.; Monte-Serrano, M.; Rodríguez-Herva, J.J.; López-Solanilla, E.; Rodríguez-Palenzuela, P.; Biosca, E.G. Exploring new roles for the rpoS gene in the survival and virulence of the fire blight pathogen Erwinia amylovora. FEMS Microbiol. Ecol. 2014, 90, 895–907. [Google Scholar] [CrossRef]
- Barbé, S.; Figàs-Segura, À.; Benada, M.; Navarro-Herrero, I.; Sampaio, T.M.; Biosca, E.G.; Marco-Noales, E. Plant-associated microbiota as a source of antagonistic bacteria against the phytopathogen Erwinia amylovora. Environ. Microbiol. Rep. 2022, 14, 559–569. [Google Scholar] [CrossRef]
- Roselló, G.; Bonaterra, A.; Francés, J.; Montesinos, L.; Badosa, E.; Montesinos, E. Biological control of fire blight of apple and pear with antagonistic Lactobacillus plantarum. Eur. J. Plant Pathol. 2013, 137, 621–633. [Google Scholar] [CrossRef]
- Cabrefiga, J.; Montesinos, E. Analysis of aggressiveness of Erwinia amylovora using disease-dose and time relationships. Phytopathology 2005, 95, 1430–1437. [Google Scholar] [CrossRef]
- Taylor, R.K.; Guilford, P.J.; Clark, R.G.; Hale, C.N.; Forster, R.L.S. Detection of Erwinia amylovora in plant material using novel polymerase chain reaction (PCR) primers. N. Z. J. Crop Hortic. Sci. 2001, 29, 35–43. [Google Scholar] [CrossRef]
- Biosca, E.G.; Amaro, C. Toxic and enzymatic activities of Vibrio vulnificus biotype 2 with respect to host specificity. Appl. Environ. Microbiol. 1996, 62, 2331–2337. [Google Scholar] [CrossRef]
- Atlas, R.M. Handbook of Microbiological Media, 3rd ed.; CRC Press: Boca Raton, FL, USA, 2004; ISBN 978-0-429-12903-2. [Google Scholar]
- Gupta, P.; Samant, K.; Sahu, A. Isolation of cellulose-degrading bacteria and determination of their cellulolytic potential. Int. J. Microbiol. 2012, 2012, 578925. [Google Scholar] [CrossRef]
- Wang, J.; Chen, Z.; Liu, Y.; Lu, F. Screening, identification and characterization of an acid α-amylase producing strain and optimization of its fermentable condition. Biotechnol. Bull. 2014, 0, 159–163. [Google Scholar]
- Norris, J.R.; Ribbons, D.W. Methods in Microbiology; Norris, J.R., Ribbons, D.W., Eds.; Academic Press: London, UK, 1969; ISBN 978-0-12-521501-5. [Google Scholar]
- Maier, T.; Klepel, S.; Renner, U.; Kostrzewa, M. Fast and reliable MALDI-TOF MS–based microorganism identification. Nat. Methods 2006, 3, i–ii. [Google Scholar] [CrossRef]
- Anonymous. Commission Decision of 30 January 2004 concerning the non-inclusion of certain active substances in Annex I to Council Directive 91/414/EEC and the withdrawal of authorisations for plant protection products containing these substances. OJEU 2004, L37, 27–31. [Google Scholar]
- Klee, S.M.; Sinn, J.P.; McNellis, T.W. The apple fruitlet model system for fire blight disease. In Plant innate Immunity; Gassmann, W., Ed.; Methods in Molecular Biology; Springer: New York, NY, USA, 2019; Volume 1991, pp. 187–198. ISBN 978-1-4939-9457-1. [Google Scholar]
- Sabri, M.; El Handi, K.; Valentini, F.; De Stradis, A.; Achbani, E.H.; Benkirane, R.; Resch, G.; Elbeaino, T. Identification and characterization of Erwinia phage IT22: A new bacteriophage-based biocontrol against Erwinia amylovora. Viruses 2022, 14, 2455. [Google Scholar] [CrossRef]
- Cui, Z.; Hu, L.; Zeng, L.; Meng, W.; Guo, D.; Sun, L. Isolation and characterization of Priestia megaterium KD7 for the biological control of pear fire blight. Front. Microbiol. 2023, 14, 1099664. [Google Scholar] [CrossRef]
- Legein, M.; Smets, W.; Vandenheuvel, D.; Eilers, T.; Muyshondt, B.; Prinsen, E.; Samson, R.; Lebeer, S. Modes of action of microbial biocontrol in the phyllosphere. Front. Microbiol. 2020, 11, 1619. [Google Scholar] [CrossRef]
- Ma, L.; Liu, T.; Zhang, K.; Shi, H.; Zhang, L.; Zou, G.; Sharon, A. Botrytis cinerea transcription factor BcXyr1 regulates hemi-cellulase production and fungal virulence. mSystems 2022, 7, e01042-22. [Google Scholar] [CrossRef] [PubMed]
- Giannelli, G.; Bisceglie, F.; Pelosi, G.; Bonati, B.; Cardarelli, M.; Antenozio, M.L.; Degola, F.; Visioli, G. Phyto-beneficial traits of rhizosphere bacteria: In vitro exploration of plant growth promoting and phytopathogen biocontrol ability of selected strains isolated from harsh environments. Plants 2022, 11, 230. [Google Scholar] [CrossRef] [PubMed]
- Rajer, F.U.; Samma, M.K.; Ali, Q.; Rajar, W.A.; Wu, H.; Raza, W.; Xie, Y.; Tahir, H.A.S.; Gao, X. Bacillus spp.-mediated growth promotion of rice seedlings and suppression of bacterial blight disease under greenhouse conditions. Pathogens 2022, 11, 1251. [Google Scholar] [CrossRef]
- Kiesewalter, H.T.; Lozano-Andrade, C.N.; Wibowo, M.; Strube, M.L.; Maróti, G.; Snyder, D.; Jørgensen, T.S.; Larsen, T.O.; Cooper, V.S.; Weber, T.; et al. Genomic and chemical diversity of Bacillus subtilis secondary metabolites against plant pathogenic fungi. mSystems 2021, 6, e00770-20. [Google Scholar] [CrossRef] [PubMed]
- Allioui, N.; Driss, F.; Dhouib, H.; Jlail, L.; Tounsi, S.; Frikha-Gargouri, O. Two novel Bacillus strains (subtilis and simplex species) with promising potential for the biocontrol of Zymoseptoria tritici, the causal agent of septoria tritici blotch of wheat. BioMed Res. Int. 2021, 2021, 6611657. [Google Scholar] [CrossRef]
- Khan, N.; Martínez-Hidalgo, P.; Ice, T.A.; Maymon, M.; Humm, E.A.; Nejat, N.; Sanders, E.R.; Kaplan, D.; Hirsch, A.M. Antifungal activity of Bacillus species against Fusarium and analysis of the potential mechanisms used in biocontrol. Front. Microbiol. 2018, 9, 2363. [Google Scholar] [CrossRef]
- Rosas-Díaz, J.; Escobar-Zepeda, A.; Adaya, L.; Rojas-Vargas, J.; Cuervo-Amaya, D.H.; Sánchez-Reyes, A.; Pardo-López, L. Paenarthrobacter sp. GOM3 is a novel marine species with monoaromatic degradation relevance. Front. Microbiol. 2021, 12, 713702. [Google Scholar] [CrossRef]
- Meng, J.; Sun, X.; Li, S.; Liang, H. Draft genome sequence of Paenarthrobacter nicotinovorans Hce-1. Genome Announc. 2017, 5, e00727-17. [Google Scholar] [CrossRef]
- Paternoster, T.; Défago, G. Selection of a biocontrol agent based on a potential mechanism of action: Degradation of nicotinic acid, a growth factor essential for Erwinia amylovora. Int. Microbiol. 2010, 13, 195–206. [Google Scholar] [CrossRef]
- Oni, F.E.; Esmaeel, Q.; Onyeka, J.T.; Adeleke, R.; Jacquard, C.; Clement, C.; Gross, H.; Ait Barka, E.; Höfte, M. Pseudomonas lipopeptide-mediated biocontrol: Chemotaxonomy and biological activity. Molecules 2022, 27, 372. [Google Scholar] [CrossRef]
- Wang, Z.; Zhang, H.; Liu, L.; Li, S.; Xie, J.; Xue, X.; Jiang, Y. Screening of phosphate-solubilizing bacteria and their abilities of phosphorus solubilization and wheat growth promotion. BMC Microbiol. 2022, 22, 296. [Google Scholar] [CrossRef]

| Strain | Host Plant | Origin | Year of Isolation | Reference |
|---|---|---|---|---|
| CFBP 1 1430 | Crataegus oxyacantha | France | 1972 | [37] |
| IVIA 2 1554 | Crataegus sp. | Segovia (Spain) | 1996 | [38] |
| IVIA 1614.2 | Pyracantha sp. | Segovia (Spain) | 1998 | [39] |
| IVIA 1892.1 | Pyrus communis | Guadalajara (Spain) | 1998 | [38] |
| Candidates | Status | E. amylovora Strains | |||
|---|---|---|---|---|---|
| CFBP 1430 | IVIA 1554 | IVIA 1614.2 | IVIA 1892.1 | ||
| UV-9 | Active | − | + | + | ++ |
| Inactive | − | + | + | ++ | |
| UV-12 | Active | − | +++ | ++ | + |
| Inactive | − | − | − | − | |
| UV-17 | Active | + | +++ | ++ | + |
| Inactive | − | +++ | + | − | |
| UV-18 | Active | ++ | +++ | +++ | +++ |
| Inactive | ++ | +++ | +++ | +++ | |
| UV-19 | Active | ++ | +++ | + | +++ |
| Inactive | + | +++ | + | ++ | |
| UV-20 | Active | + | +++ | ++ | ++ |
| Inactive | − | ++ | + | + | |
| UV-30 | Active | − | +++ | ++ | ++ |
| Inactive | − | − | − | − | |
| UV-41 | Active | ++ | ++ | ++ | ++ |
| Inactive | ++ | ++ | ++ | ++ | |
| UV-59 | Active | − | − | ++ | + |
| Inactive | − | − | ++ | + | |
| UV-60 | Active | − | − | ++ | − |
| Inactive | − | − | ++ | − | |
| Bacterial Isolate | Exoenzymatic Activity 1 | Nitrogen-Fixing Activity 2 | |||||||
|---|---|---|---|---|---|---|---|---|---|
| Protease | Lipase | Amylase | Cellulase | DNase | |||||
| 48 h | 96 h | 48 h | 96 h | 96 h | 96 h | 96 h | 48 h | 96 h | |
| UV-9 | +++ | +++ | +++ | +++ | +++ | +++ | + | − | − |
| UV-12 | ++ | ++ | − | ++ | − | − | + | + | + |
| UV-17 | − | ++ | − | − | +++ | − | + | + | + |
| UV-18 | ++ | +++ | − | − | +++ | − | + | − | + |
| UV-19 | ++ | +++ | − | − | +++ | − | + | − | + |
| UV-20 | − | ++ | − | − | +++ | − | − | + | + |
| UV-30 | − | − | − | ++ | − | − | − | + | + |
| UV-41 | − | ++ | + | +++ | +++ | +++ | − | − | − |
| UV-59 | − | − | − | − | +++ | − | + | − | − |
| UV-60 | − | − | − | − | +++ | − | + | − | − |
| Strain Code | Identification (Matched Pattern) | Score Value 1 |
|---|---|---|
| UV-12 | Bacillus simplex CS 206_1aI BRB | 1.91 (+) |
| UV-17 | Paenarthrobacter aurescens DSM 20116T | 2.34 (+++) |
| UV-20 | Paenarthrobacter nicotinovorans DSM 420T | 1.86 (+) |
| UV-30 | Pseudomonas moraviensis DSM 16007T | 2.39 (+++) |
Disclaimer/Publisher’s Note: The statements, opinions and data contained in all publications are solely those of the individual author(s) and contributor(s) and not of MDPI and/or the editor(s). MDPI and/or the editor(s) disclaim responsibility for any injury to people or property resulting from any ideas, methods, instructions or products referred to in the content. |
© 2023 by the authors. Licensee MDPI, Basel, Switzerland. This article is an open access article distributed under the terms and conditions of the Creative Commons Attribution (CC BY) license (https://creativecommons.org/licenses/by/4.0/).
Share and Cite
Esteban-Herrero, G.; Álvarez, B.; Santander, R.D.; Biosca, E.G. Screening for Novel Beneficial Environmental Bacteria for an Antagonism-Based Erwinia amylovora Biological Control. Microorganisms 2023, 11, 1795. https://doi.org/10.3390/microorganisms11071795
Esteban-Herrero G, Álvarez B, Santander RD, Biosca EG. Screening for Novel Beneficial Environmental Bacteria for an Antagonism-Based Erwinia amylovora Biological Control. Microorganisms. 2023; 11(7):1795. https://doi.org/10.3390/microorganisms11071795
Chicago/Turabian StyleEsteban-Herrero, Guillermo, Belén Álvarez, Ricardo D. Santander, and Elena G. Biosca. 2023. "Screening for Novel Beneficial Environmental Bacteria for an Antagonism-Based Erwinia amylovora Biological Control" Microorganisms 11, no. 7: 1795. https://doi.org/10.3390/microorganisms11071795
APA StyleEsteban-Herrero, G., Álvarez, B., Santander, R. D., & Biosca, E. G. (2023). Screening for Novel Beneficial Environmental Bacteria for an Antagonism-Based Erwinia amylovora Biological Control. Microorganisms, 11(7), 1795. https://doi.org/10.3390/microorganisms11071795

